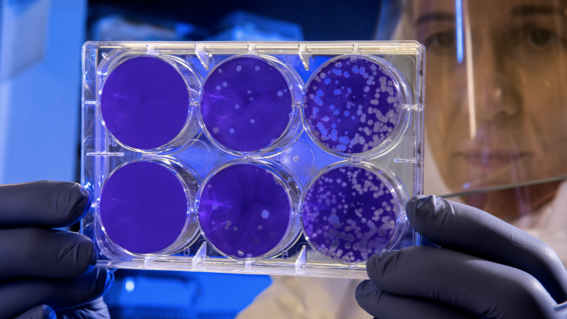

EEUU inició etapa de pruebas de posible vacuna contra coronavirus
Una empresa farmacéutica de Estados Unidos sometió al análisis de investigadores del Gobierno una posible vacuna que está enfocada en combatir el coronavirus “Covid-19” que ha infectado a más de 80.000 personas.
Lea también: Diputado Javier Hernández:El Estado debe entregar las herramientas y la protección a la policía
Según reseñó FayerWayer, la compañía de biotecnología Moderna, envío una serie de análisis al Instituto Nacional de Enfermedades Alérgicas e Infecciosas para realizar pruebas en etapas tempranas de afectados en los Estados Unidos.
El coronavirus ha causado la muerte de más de 2.600 personas en China continental, además de la muerte de un ciudadano estadounidense. Actualmente en el país norteamericano 35 personas sufren de esta enfermedad.
Por su parte, la Organización Mundial de la Salud (OMS) todavía no ha definido de pandemia el coronavirus, sin embargo activaron la alerta para buscar una vacuna temprana.


